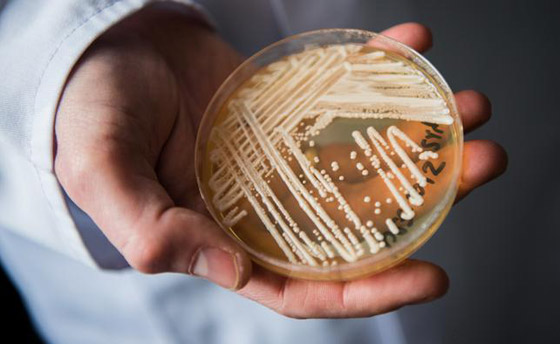
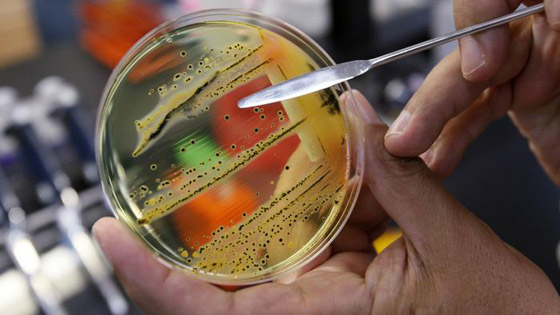

يؤدي سوء استخدام المضادات الحيوية، والإفراط في استعمالها سواء في الطب أو الزراعة إلى ظهور جراثيم بكتيرية قاتلة ومُقاومة للأدوية. ألبوم الصور التالي يُقدم إليك بعض الجراثيم الخطيرة والمنتشرة في مناطق متفرقة حول العالم. فتعرفوا معنا على أخطر الجراثيم القاتلة في العالم.
1. الكانديدا أوريس: الكانديدا أوريس أو المبيضات أوريس، هي نوع من أنواع الفطريات (الخمائر). وقد أظهرت هذه الفطريات مقاومتها لعقاقير متعددة مضادة للفطريات، والتي تستخدم عادة لعلاج عدوى المبيضات. كما ظهرت هذه الفطريات في القارات الخمس حتى الآن، وكان من الصعب التخلص منها، لدرجة دفعت بعض المستشفيات إلى إغلاق أبوابها، من أجل التغلب عليها.

2. الزائفة الزنجارية: صنفت منظمة الصحة العالمية الزائفة الزنجارية (بكتيريا شديدة المقاومة) كواحدة من أكبر الأخطار التي تُهدد صحة الإنسان. زيادة على ذلك، تُعد الزائفة الزنجارية واحدة من أكثر جراثيم المستشفيات شيوعاً. ويُمكن رؤية هذه البكتيريا بشكل خاص لدى الأشخاص، الذين يُعانون من نقص المناعة.

3. بكتيريا النيسرية البنية: لا يُوجد لقاح ضد السيلان، لذلك فإن المضادات الحيوية هي الخيار الوحيد لعلاج العدوى. وينتقل هذا المرض بالاتصال الحميمي ويقاوم بشكل متزايد الأدوية التي تستخدم عادة في العلاج. وفي السنة الماضية تم الإبلاغ عن حالتين من مرض السيلان (بكتيريا النيسرية البنية هي المسؤولة عن مرض السيلان) الفائق في أستراليا. فضلاً عن حالتين أخريين في بريطانيا بداية هذه السنة.
4. بكتيريا السلمونيلا: يمكن أن تُسبب العدوى بالسلمونيلا أمراضاً مختلفة على غرار: التيفوئيد والحمى نظيرة التيفية أو التهاب الأمعاء. وتنتشر السلمونيلا عن طريق الأغذية والمياه الملوثة، إذ تعاني منها بعض المناطق في قارتي أفريقيا وآسيا.

5. الراكدة البومانية: صنفت منظمة الصحة العالمية الراكدة البومانية ضمن الفئة الأكثر خطورة من مسببات المرض. وتوجد هذه البكتيريا بشكل شائع في التربة والمياه. كما أنها تستطيع البقاء على قيد الحياة داخل أجسام الأشخاص الأصحاء، وذلك دون التسبب في أعراض، فيما يمكن أن تُسبب للمرضى التهابات مميتة في الرئة والتهاب الدم.

6. السل المقاوم للعقاقير: تعد المتفطرة السُلية (بكتيريا تتسبب في السل) من أكثر الأمراض المعدية شيوعاً في العالم، حيث يتسبب هذا المرض في وفاة أكثر من 1.7 مليون شخص سنوياً. وتشير التقديرات إلى أن ما يصل إلى 6 في المائة من جميع حالات السل الجديدة مقاومة للعقاقير، ولم تعد تستجيب لطرق العلاج الأكثر فعالية.